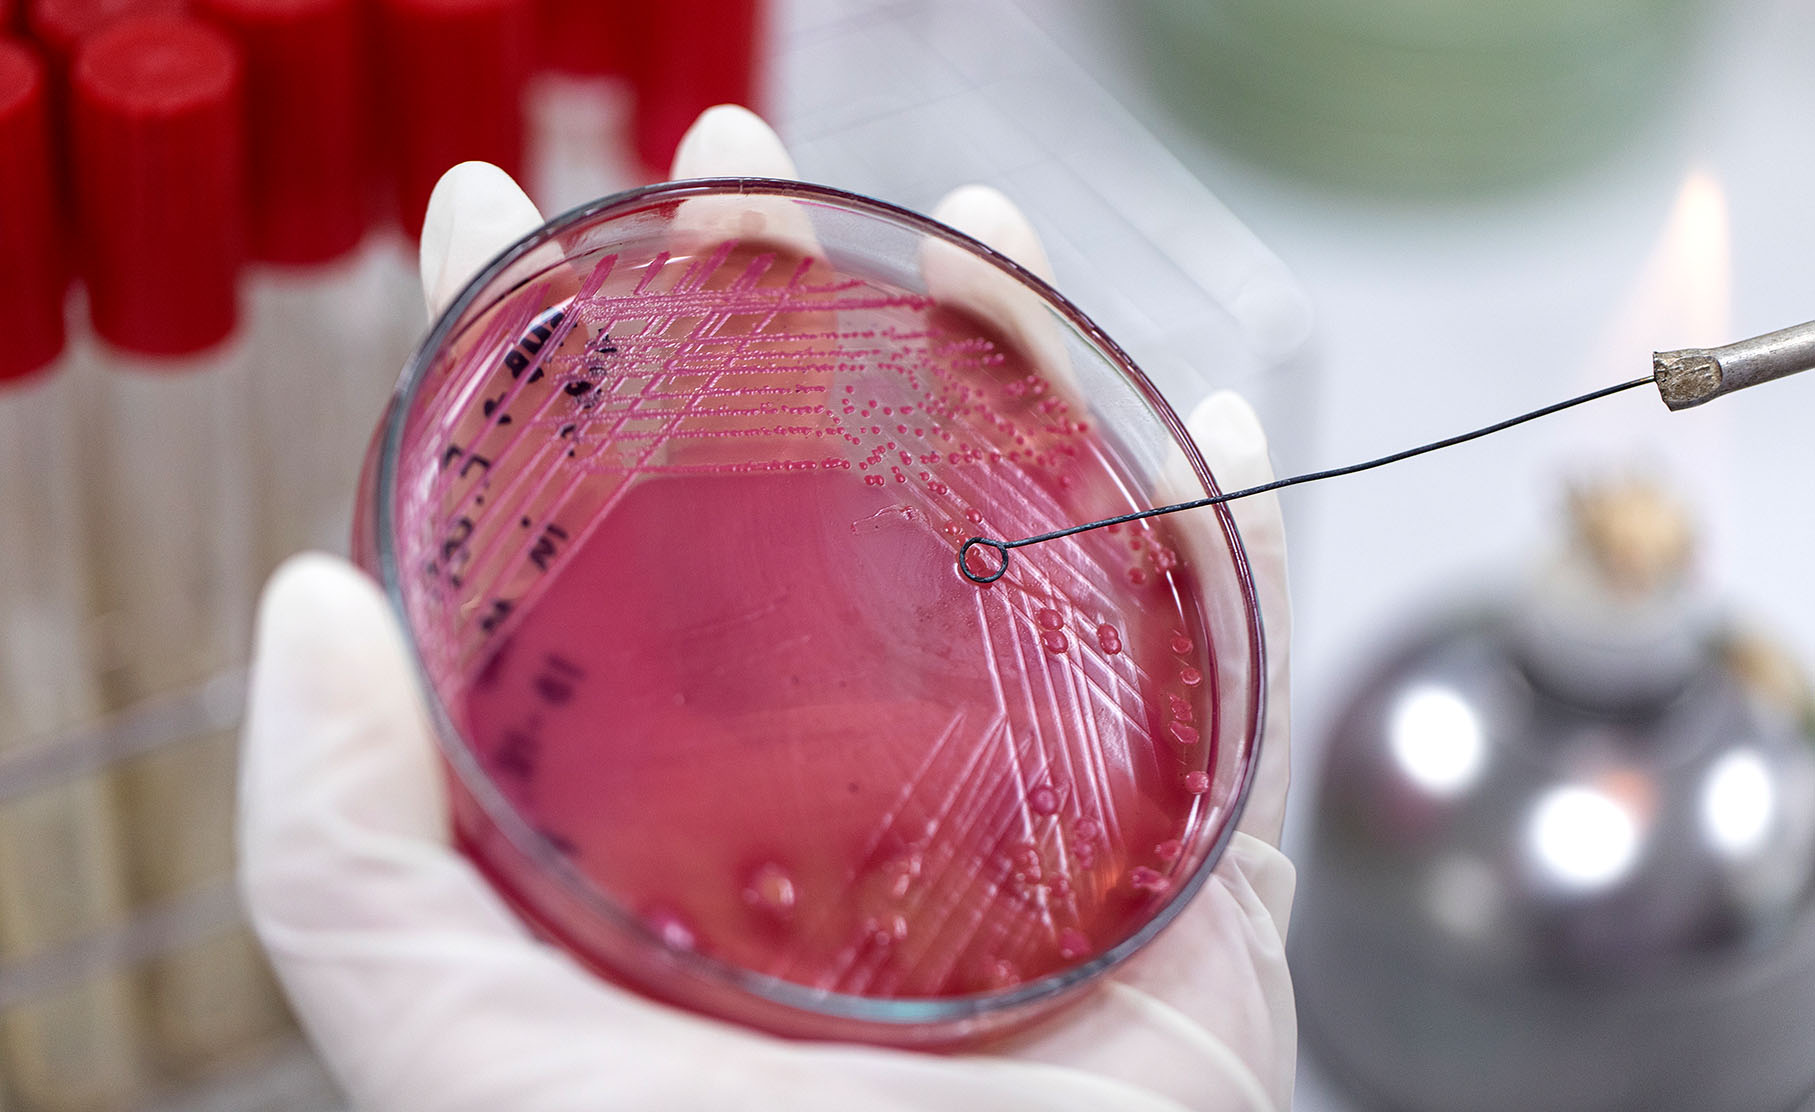
How vaccines could help combat drug resistance and transform SA's public health outcomes

Antimicrobial resistance (AMR) has emerged as one of the most significant public health threats of our time, a crisis faced by many countries, including South Africa.
As microbes adapt and become resistant to traditional antibiotics and other antimicrobial agents, treating infectious diseases becomes increasingly difficult.
However, what most people don’t know about antibiotics is that we use them not only to treat infections, but also to prevent infections during surgeries and when taking immunosuppressive therapies.
Antibiotics save lives and have been shown to add an average of 23 years to global life expectancy. Without effective antibiotics, even minor surgeries and routine medical procedures could become high-risk as infections may no longer be treatable.
In 2021, South Africa reported 77,784 deaths due to bacterial infections. Of these deaths, 35,054 were associated with AMR (a drug-resistant infection was implicated in their death, but did not necessarily cause it), and 8,485 were attributable to AMR (bacterial resistance to antibiotics caused their death).
Despite this high morbidity and mortality, AMR remains a neglected pandemic and uneven burden across the world.
AMR disproportionately impacts people living in poverty, who often face barriers to accessing healthcare and essential resources such as clean water, sanitation and hygiene infrastructure.
Without affordable and timely access to healthcare, many delay treatment, self-medicate, or use substandard antibiotics — practices that fuel the spread of drug-resistant infections.
In low-resource settings, crowded living conditions, environmental pollution and the widespread use of antibiotics in livestock further drive AMR. Poor access to diagnostics and limited antibiotic options worsen the problem.
Ultimately, poverty increases vulnerability to AMR, emphasising the urgent need to expand access to fundamental rights like healthcare access, sanitation, education and vaccination to protect communities and reduce the global burden of resistance.
The World Health Organization outlines five main principles in its global action plan to tackle AMR . They are:
- Reduce the number of infections through vaccination, improved water, sanitation and hygiene (Wash), and strengthening infection prevention and control (IPC) in health facilities and communities.
- Optimal use of antibiotics through antimicrobial stewardship. Using appropriate antibiotics at the right time, as needed, and reducing unnecessary use.
- Research and innovation to develop new antibiotics and vaccines and improve diagnostic tests that quickly differentiate between bacterial and viral infections.
- Raise awareness by emphasising AMR as a serious issue to the public, and educating healthcare workers to encourage responsible antibiotic use.
- Increase surveillance of AMR nationally and globally.
Due to the higher burden of infectious diseases in low-resource countries, the first principle — reducing the number of infections — is particularly crucial. By preventing infections, we can improve people’s wellbeing and livelihoods and reduce our reliance on antibiotics.
Additionally, we significantly reduce healthcare costs associated with AMR, including longer hospital stays and more expensive treatments. Vaccination stands out as one of the most powerful and cost-effective tools available to achieve these goals, with strong evidence showing that broad immunisation coverage significantly reduces AMR prevalence.
By preventing infections, vaccines limit the emergence and transmission of susceptible and drug-resistant strains, lower the risk of secondary infections and reduce the need for antimicrobial use.
However, there is little to no integration between AMR and vaccination strategies.
Impact of vaccines on AMR in South Africa
The following examples illustrate how existing vaccines in the routine immunisation programme could reduce morbidity, mortality and antibiotic use.
- Three years after its introduction in 2009, the pneumococcal conjugate vaccine (PCV) led to a significant decrease in the rate of invasive pneumococcal disease caused by penicillin-resistant isolates in children under two years old. Additionally, PCV prevents seven out of 100 cases of antibiotic-treated acute respiratory illness (ARI) annually.
- Vaccines targeting viruses can mitigate AMR by lowering the occurrence of secondary bacterial infections. Additionally, they lower the number of viral infections that are inappropriately treated with antibiotics.
- The rotavirus vaccine could prevent an estimated six out of 100 (6%) cases of antibiotic-treated diarrhoea in children under two years of age annually.
- The maternal respiratory syncytial virus (RSV) vaccine was shown to reduce the number of antibiotic prescriptions in the first three months of life.
- Vaccinating just 30% of the population aged over 65 years against seasonal influenza could avert more than 11,000 inappropriate antibiotic prescriptions each year.
Along with the existing vaccines, other candidates in development are projected to have a great impact. A hypothetical tuberculosis (TB) vaccine was projected to avert 10,000 cases of rifampicin-resistant TB (RR-TB) and 2,900 RR-TB deaths over 15 years in South Africa.
A potential maternal vaccine targeting Klebsiella pneumoniae was estimated to prevent 1,717 cases of newborn sepsis and 344 newborn deaths each year, helping to reduce about 4% of all deaths from neonatal sepsis.
Other measures to prevent infections
A modelling analysis has shown that reducing the global AMR burden by 10% by 2030 is achievable with existing interventions. Improved access to clean water, sanitation and hygiene, as well as aligning infection prevention standards in hospitals with those in high-income countries, could prevent 247,800 and 337,000 AMR-associated deaths annually, respectively.
Achieving universal coverage of important childhood vaccinations was estimated to prevent up to 181,500 AMR-associated deaths annually.
Together, the implementation of these interventions could have a strong impact on the avoidable burden of AMR and other adverse health outcomes in low- to middle-income countries.
In 2024, more than 14 million children did not receive any vaccine doses. Amid competing domestic public health priorities and a decline in global health funding, vaccine access in low- to middle-income countries faces further risks.
Africa CDC has prioritised expanding local vaccine manufacturing to bolster the continent’s health security. Increasing domestic production allows African nations to reduce dependence on imports, which often face logistical delays and high costs.
In 2021, Africa CDC set an ambitious goal: for Africa to produce 60% of its vaccine needs by 2040 (up from less than 1% at that time). These efforts are vital for Africa’s ability to respond to pandemics and endemic diseases, and to tackle broader public health issues like AMR through improved vaccine access.
AMR is already costing too many lives and straining health systems. We have existing interventions — vaccines, improved water, sanitation and hygiene measures, infection prevention in hospitals, and antimicrobial stewardship — which, if implemented effectively, could prevent infections, slow drug resistance, and ease the enormous health and economic burden AMR brings.
As foreign aid declines and healthcare costs rise, the need for cost-effective prevention has never been greater. Vaccination must become a core pillar of AMR strategies, as preventing infections is far more cost-effective than treating them. DM
A policy brief on this topic will be publicly launched in early October. The technical working group that did the work formed part of a project called The Global Antibiotic Partnership — South Africa (GARP-SA), and included a range of experts from academia, the National Department of Health, the private sector, and the non-profit sector and was chaired by Professor Adrian Brink from the University of Cape Town.
Dr Elloise du Toit is an Antimicrobial Resistance (AMR) consultant and microbiologist with more than a decade of experience spanning academia, public health and global health policy. She holds a PhD in Molecular and Cell Biology from the University of Cape Town, where she is completing a Master’s in Public Health.
Dr Erta Kalanxhi is a Fellow and Director of Partnerships at the One Health Trust, where she leads initiatives that highlight the vital role vaccines play in addressing the problem of drug-resistant infections.
Professor Adrian J Brink is the Wernher and Beit Professor and Chair; Head of the Division of Medical Microbiology at the Faculty of Health Sciences, University of Cape Town. His work spans antimicrobial resistance, microbiome research, pharmacokinetics and antimicrobial stewardship. He serves as Associate Editor for the Journal of Antimicrobial Chemotherapy.

Antimicrobial resistance (AMR) has emerged as one of the most significant public health threats of our time, a crisis that many countries, including South Africa, are currently facing.
(Photo: iStock)
Antimicrobial resistance (AMR) has emerged as one of the most significant public health threats of our time, a crisis that many countries, including South Africa, are currently facing.
(Photo: iStock)